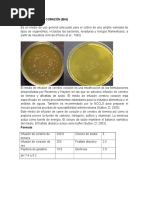

0% encontró este documento útil (0 votos)
189 vistas8 páginasMedios de Cultivo en Microbiología Clínica
Este documento describe varios medios de cultivo comúnmente utilizados en microbiología clínica, incluyendo su composición y uso. Algunos medios como el agar BCYE, BHI, chocolate y Sabouraud se utilizan para el crecimiento de una amplia gama de microorganismos, mientras que otros como CIN, CCF y EMB son más selectivos. Cada medio tiene propiedades diferenciales que permiten el aislamiento y diferenciación de bacterias y hongos específicos.
Cargado por
helenaDerechos de autor
© © All Rights Reserved
Nos tomamos en serio los derechos de los contenidos. Si sospechas que se trata de tu contenido, reclámalo aquí.
Formatos disponibles
Descarga como DOCX, PDF, TXT o lee en línea desde Scribd
0% encontró este documento útil (0 votos)
189 vistas8 páginasMedios de Cultivo en Microbiología Clínica
Este documento describe varios medios de cultivo comúnmente utilizados en microbiología clínica, incluyendo su composición y uso. Algunos medios como el agar BCYE, BHI, chocolate y Sabouraud se utilizan para el crecimiento de una amplia gama de microorganismos, mientras que otros como CIN, CCF y EMB son más selectivos. Cada medio tiene propiedades diferenciales que permiten el aislamiento y diferenciación de bacterias y hongos específicos.
Cargado por
helenaDerechos de autor
© © All Rights Reserved
Nos tomamos en serio los derechos de los contenidos. Si sospechas que se trata de tu contenido, reclámalo aquí.
Formatos disponibles
Descarga como DOCX, PDF, TXT o lee en línea desde Scribd